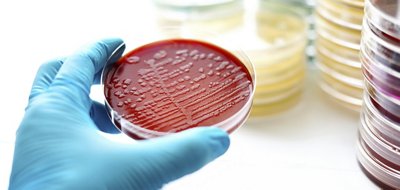

June 30, 2026
bioMérieux submits 510(k) to U.S. FDA for the latest versions of the BIOFIRE® FILMARRAY® Gastrointestinal Panels to enhance detection of gastrointestinal pathogens
bioMérieux, a world leader in the field of in vitro diagnostics, today announces the submission of the BIOFIRE® FILMARRAY® Gastrointestinal 1.1 (GI1.1) Panel and the BIOFIRE® FILMARRAY® Gastrointestinal 1.1 (GI1.1) Panel Mid to the U.S. Food and Drug Administration (FDA) for 510(k) review. These PCR* molecular panels test 22 and 11, respectively, of the most common bacteria, viruses, and parasites associated with gastroenteritis, all from one sample, with results available in approximately one hour.